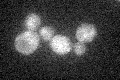
YGR004W
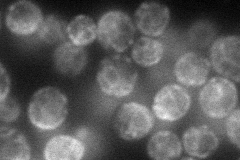
YGR004W
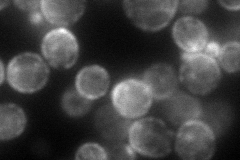
YGR004W
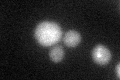
YGR004W

View description
Peroxisomal integral membrane protein, involved in negative regulation of peroxisome size; partially functionally redundant with Pex30p and Pex32p; probably acts at a step downstream of steps mediated by Pex28p and Pex29p
Localization:
Intensity:
Fold change:
Significance:
-
C’ GFP library in SD
cytosol21.28 -
N' NOP1pr-GFP in SD
cell periphery,ER,punctate63.2115 -
N' TEF2pr-mCherry in SD
cell periphery,ER,punctate85.8256 -
N' NATIVEpr-GFP in SD

ambiguous,ER,bud23.566 -
N' TEF2pr-VC and Cyto-VN in SD

punctate32.732 -
C’ GFP library in SD+DTT
cytosol24.581.15No -
C’ GFP library in SD+H2O2

cytosol23.381.09No -
C’ GFP library in Starvation Media

cytosol17.10.8No -
C’ GFP library on the background of Pup2-DaMP

N/A -
C’ GFP library on the background of CCT mutant

N/A0N/AYes
